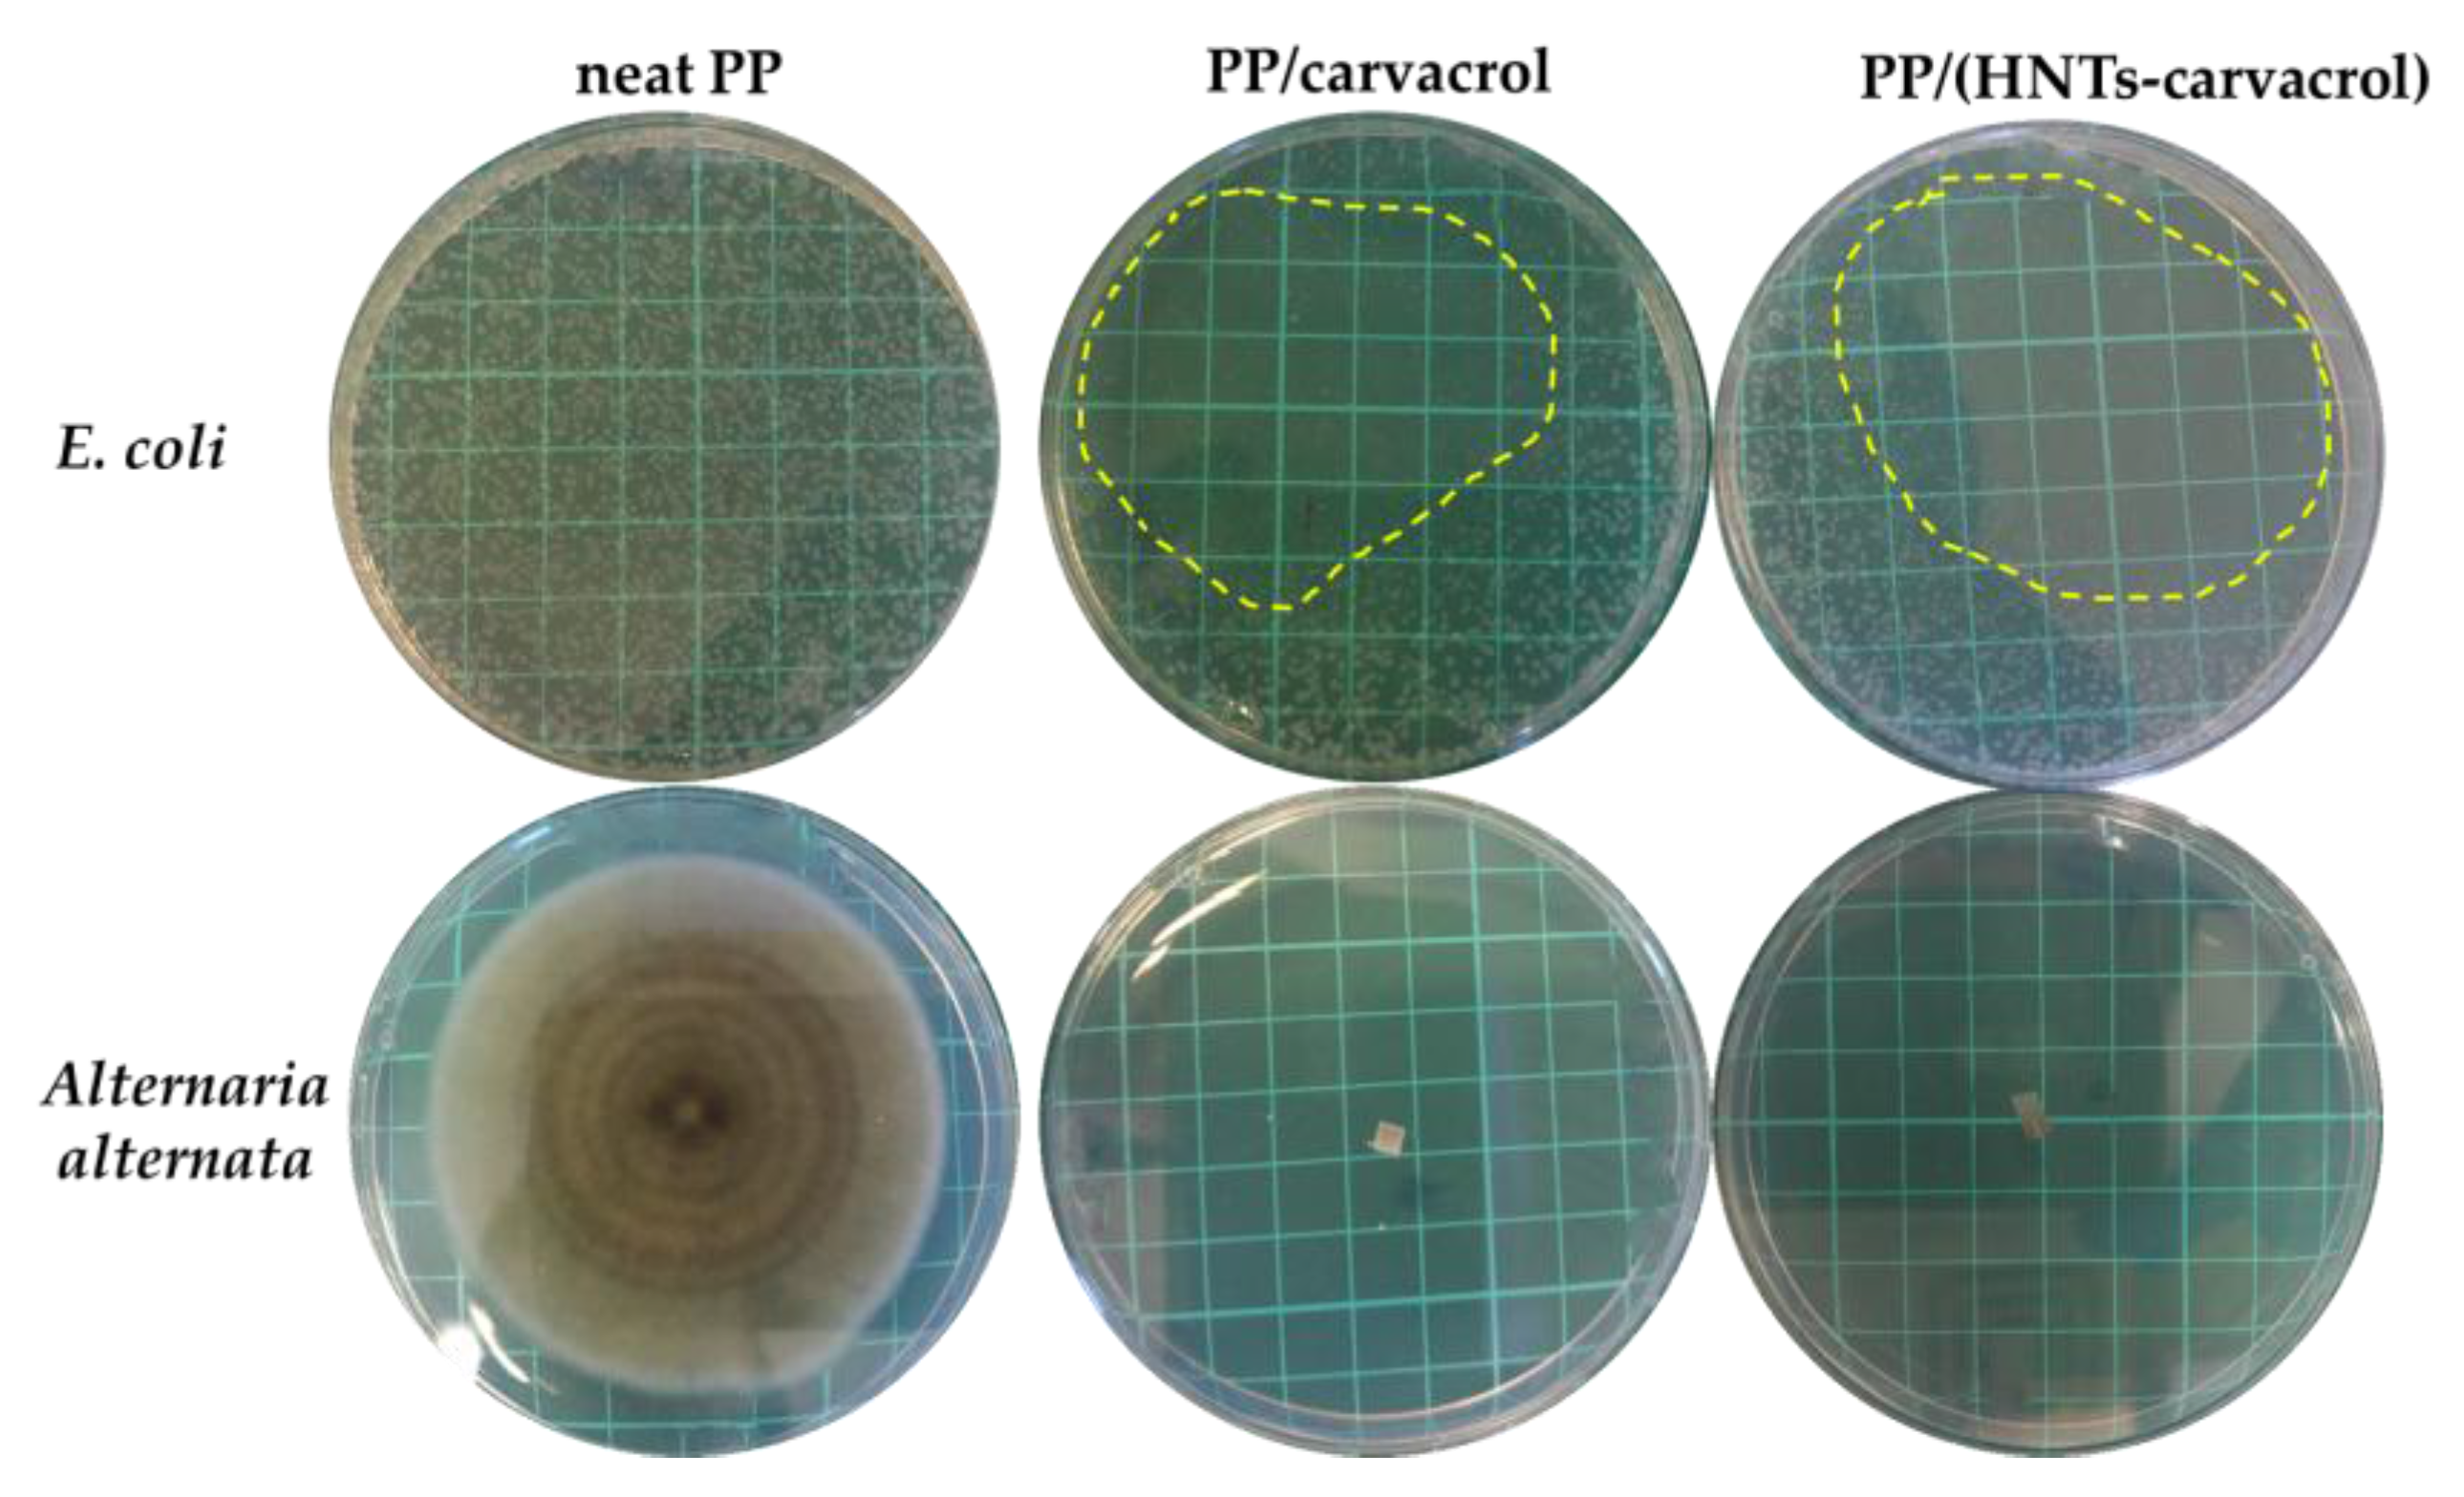
Polymers 10 00079 g006

Antimicrobial Carvacrol-Containing Polypropylene Films: Composition, Structure and Function
Abstract
1. Introduction
2. Materials and Methods
2.1. Materials
2.2. Preparation of HNTs Loaded with Carvacrol
2.3. Preparation of PP Films
2.4. Characterization of Films
2.4.1. High-Resolution Scanning Electron Microscopy
2.4.2. Thermal Gravimetric Analysis (TGA)
2.4.3. Infrared Spectroscopy
2.4.4. Differential Scanning Calorimetry (DSC)
2.4.5. Wide-Angle X-ray (WAXS) Diffraction
2.4.6. Carvacrol Release Studies
2.4.7. Mechanical Analysis
2.4.8. Antimicrobial Assays
2.4.9. Molecular Dynamics Simulations
3. Results
3.1. Films Morphology and Composition
3.2. Interactions between PP, HNTs and Carvacrol by Molecular Dynamics Simulations
3.3. Polypropylene Crystalline and Amorphous Phases (DSC, FTIR, WAXS)
3.4. Mechanical Properties
3.5. Release Studies and Antimicrobial Activity
4. Conclusions
Supplementary Materials
Acknowledgments
Author Contributions
Conflicts of Interest
References
- Kenawy, E.-R.; Worley, S.D.; Broughton, R. The chemistry and applications of antimicrobial polymers: A state-of-the-art review. Biomacromolecules 2007, 8, 1359–1384. [Google Scholar] [CrossRef] [PubMed]
- Xu, X.; Xiao, H.; Ziaee, Z.; Wang, H.; Guan, Y.; Zheng, A. Novel comb-like ionenes with aliphatic side chains: Synthesis and antimicrobial properties. J. Mater. Sci. 2013, 48, 1162–1171. [Google Scholar] [CrossRef]
- Corrales, M.; Fernández, A.; Han, J.H. Chapter 7—Antimicrobial packaging systems. In Innovations in Food Packaging, 2nd ed.; Han, J.H., Ed.; Academic Press: San Diego, CA, USA, 2014; pp. 133–170. [Google Scholar]
- Song, J.; Jang, J. Antimicrobial polymer nanostructures: Synthetic route, mechanism of action and perspective. Adv. Colloid Interface Sci. 2014, 203, 37–50. [Google Scholar] [CrossRef] [PubMed]
- Gaillet, S.; Rouanet, J.-M. Silver nanoparticles: Their potential toxic effects after oral exposure and underlying mechanisms—A review. Food Chem. Toxicol. 2015, 77, 58–63. [Google Scholar] [CrossRef] [PubMed]
- Han, J.H. Antimicrobial packaging systems. In Innovations in Food Packaging, 1st ed.; Han, J.H., Ed.; Academic Press: San Diego, CA, USA, 2005. [Google Scholar]
- Irkin, R.; Esmer, O. Novel food packaging systems with natural antimicrobial agents. J. Food Sci. Technol. 2015, 52, 6095–6111. [Google Scholar] [CrossRef] [PubMed]
- Vergis, J.; Gokulakrishnan, P.; Agarwal, R.K.; Kumar, A. Essential Oils as Natural Food Antimicrobial Agents: A Review. Crit. Rev. Food Sci. Nutr. 2013, 55, 1320–1323. [Google Scholar] [CrossRef] [PubMed]
- Dorman, H.J.D.; Deans, S.G. Antimicrobial agents from plants: Antibacterial activity of plant volatile oils. J. Appl. Microbiol. 2000, 88, 308–316. [Google Scholar] [CrossRef] [PubMed]
- Burt, S.A. Essential oils: Their antibacterial properties and potential applications in foods—A review. Int. J. Food Microbiol. 2004, 94, 223–253. [Google Scholar] [CrossRef] [PubMed]
- Moreira, M.R.; Alvarez, M.V.; Ponce, A.G. Essential Oils; Springer: Cham, Switzerland, 2016; pp. 113–124. [Google Scholar]
- Calo, J.R.; Crandall, P.G.; O’Bryan, C.A.; Ricke, S.C. Essential oils as antimicrobials in food systems—A review. Food Control 2015, 54, 111–119. [Google Scholar] [CrossRef]
- Hyldgaard, M.; Mygind, T.; Meyer, R.L. Essential oils in food preservation: Mode of action, synergies, and interactions with food matrix components. Front. Microbiol. 2012, 3. [Google Scholar] [CrossRef] [PubMed]
- Bassolé, I.H.N.; Juliani, H.R. Essential Oils in Combination and Their Antimicrobial Properties. Molecules 2012, 17, 3989–4006. [Google Scholar] [CrossRef] [PubMed]
- Malhotra, B.; Keshwani, A.; Kharkwal, H. Antimicrobial food packaging: Potential and pitfalls. Front. Microbiol. 2015, 6, 611. [Google Scholar] [CrossRef] [PubMed]
- Ramos, M.; Jiménez, A.; Peltzer, M.; Garrigós, M.C. Characterization and antimicrobial activity studies of polypropylene films with carvacrol and thymol for active packaging. J. Food Eng. 2012, 109, 513–519. [Google Scholar] [CrossRef]
- Sung, S.-Y.; Sin, L.T.; Tee, T.-T.; Bee, S.-T.; Rahmat, A.R.; Rahman, W.A.W.A.; Tan, A.-C.; Vikhraman, M. Antimicrobial agents for food packaging applications. Trends Food Sci. Technol. 2013, 33, 110–123. [Google Scholar] [CrossRef]
- Suppakul, P.; Miltz, J.; Sonneveld, K.; Bigger, S.W. Characterization of antimicrobial films containing basil extracts. Packag. Technol. Sci. 2006, 19, 259–268. [Google Scholar] [CrossRef]
- Valdés, A.; Mellinas, A.C.; Ramos, M.; Burgos, N.; Jiménez, A.; Garrigós, M.C. Use of herbs, spices and their bioactive compounds in active food packaging. RSC Adv. 2015, 5, 40324–40335. [Google Scholar] [CrossRef]
- Shemesh, R.; Goldman, D.; Krepker, M.; Danin-Poleg, Y.; Kashi, Y.; Vaxman, A.; Segal, E. LDPE/clay/carvacrol nanocomposites with prolonged antimicrobial activity. J. Appl. Polym. Sci. 2015, 132, 41261. [Google Scholar] [CrossRef]
- Shemesh, R.; Krepker, M.; Goldman, D.; Danin-Poleg, Y.; Kashi, Y.; Nitzan, N.; Vaxman, A.; Segal, E. Antibacterial and antifungal LDPE films for active packaging. Polym. Adv. Technol. 2015, 26, 110–116. [Google Scholar] [CrossRef]
- Persico, P.; Ambrogi, V.; Carfagna, C.; Cerruti, P.; Ferrocino, I.; Mauriello, G. Nanocomposite polymer films containing carvacrol for antimicrobial active packaging. Polym. Eng. Sci. 2009, 49, 1447–1455. [Google Scholar] [CrossRef]
- Liu, M.; Jia, Z.; Jia, D.; Zhou, C. Recent advance in research on halloysite nanotubes-polymer nanocomposite. Prog. Polym. Sci. 2014, 39, 1498–1525. [Google Scholar] [CrossRef]
- Lvov, Y.M.; Price, R.R. Halloysite Nanotubules, a Novel Substrate for the Controlled Delivery of Bioactive Molecules. In Bio-Inorganic Hybrid Nanomaterials; Wiley-VCH Verlag GmbH & Co., KGaA: Weinheim, Germany, 2008; pp. 419–441. [Google Scholar]
- Veerabadran, N.G.; Price, R.R.; Lvov, Y.M. Clay nanotubes for encapsulation and sustained release of drugs. Nano 2007, 2, 115–120. [Google Scholar] [CrossRef]
- Lvov, Y.M.; Shchukin, D.G.; Mohwald, H.; Price, R.R. Halloysite clay nanotubes for controlled release of protective agents. ACS Nano 2008, 2, 814–820. [Google Scholar] [CrossRef] [PubMed]
- Lvov, Y.; Abdullayev, E. Functional polymer–clay nanotube composites with sustained release of chemical agents. Prog. Polym. Sci. 2013, 38, 1690–1719. [Google Scholar] [CrossRef]
- Abdullayev, E.; Lvov, Y. Halloysite clay nanotubes for controlled release of protective agents. J. Nanosci. Nanotechnol. 2011, 11, 10007–10026. [Google Scholar] [CrossRef] [PubMed]
- Cavallaro, G.; Lazzara, G.; Milioto, S.; Parisi, F.; Sanzillo, V. Modified halloysite nanotubes: Nanoarchitectures for enhancing the capture of oils from vapor and liquid phases. ACS Appl. Mater. Interfaces 2014, 6, 606–612. [Google Scholar] [CrossRef] [PubMed]
- Du, M.; Guo, B.; Jia, D. Newly emerging applications of halloysite nanotubes: A review. Polym. Int. 2010, 59, 574–582. [Google Scholar] [CrossRef]
- Jia, Z.; Luo, Y.; Guo, B.; Yang, B.; Du, M.; Jia, D. Reinforcing and flame-retardant effects of halloysite nanotubes on LLDPE. Polym. Plast. Technol. Eng. 2009, 48, 607–613. [Google Scholar] [CrossRef]
- Lecouvet, B.; Gutierrez, J.G.; Sclavons, M.; Bailly, C. Structure-property relationships in polyamide 12/halloysite nanotube nanocomposites. Polym. Degrad. Stabil. 2011, 96, 226–235. [Google Scholar] [CrossRef]
- Cavallaro, G.; Donato, D.I.; Lazzara, G.; Milioto, S. Films of halloysite nanotubes sandwiched between two layers of biopolymer: From the morphology to the dielectric, thermal, transparency, and wettability properties. J. Phys. Chem. C 2011, 115, 20491–20498. [Google Scholar] [CrossRef]
- Krepker, M.; Shemesh, R.; Danin Poleg, Y.; Kashi, Y.; Vaxman, A.; Segal, E. Active food packaging films with synergistic antimicrobial activity. Food Control 2017, 76, 117–126. [Google Scholar] [CrossRef]
- Shemesh, R.; Krepker, M.; Natan, M.; Danin-Poleg, Y.; Banin, E.; Kashi, Y.; Nitzan, N.; Vaxman, A.; Segal, E. Novel LDPE/halloysite nanotube films with sustained carvacrol release for broad-spectrum antimicrobial activity. RSC Adv. 2015, 5, 87108–87117. [Google Scholar] [CrossRef]
- Shemesh, R.; Krepker, M.; Nitzan, N.; Vaxman, A.; Segal, E. Active packaging containing encapsulated carvacrol for control of postharvest decay. Postharvest Biol. Technol. 2016, 118, 175–182. [Google Scholar] [CrossRef]
- Amaral, V.C.S.; Santos, P.R.; da Silva, A.F.; dos Santos, A.R.; Machinski, M.; Mikcha, J.M.G. Effect of carvacrol and thymol on salmonella spp. Biofilms on polypropylene. Int. J. Food Sci. Technol. 2015, 50, 2639–2643. [Google Scholar] [CrossRef]
- Han, C.; Wang, J.; Li, Y.; Lu, F.; Cui, Y. Antimicrobial-coated polypropylene films with polyvinyl alcohol in packaging of fresh beef. Meat Sci. 2014, 96, 901–907. [Google Scholar] [CrossRef] [PubMed]
- López, P.; Sánchez, C.; Batlle, R.; Nerín, C. Development of flexible antimicrobial films using essential oils as active agents. J. Agric. Food Chem. 2007, 55, 8814–8824. [Google Scholar] [CrossRef] [PubMed]
- Muriel-Galet, V.; Cerisuelo, J.P.; López-Carballo, G.; Lara, M.; Gavara, R.; Hernández-Muñoz, P. Development of antimicrobial films for microbiological control of packaged salad. Int. J. Food Microbiol. 2012, 157, 195–201. [Google Scholar] [CrossRef] [PubMed]
- Koivisto, A.J.; Brostrøm, A.; Kling, K.I.; Fonseca, A.S.; Redant, E.; Andrade, F.; Hougaard, K.S.; Krepker, M.; Setter-Prinz, O.; Segal, E.; et al. Occupational exposure during handling and loading of halloysite nanotubes—A case study of counting nanofibers. J. Hazard. Mater. 2017. in review. [Google Scholar]
- Ning, N.-Y.; Yin, Q.-J.; Luo, F.; Zhang, Q.; Du, R.; Fu, Q. Crystallization behavior and mechanical properties of polypropylene/halloysite composites. Polymer 2007, 48, 7374–7384. [Google Scholar] [CrossRef]
- ASTM-E1356. Standard Test Method for Assignment of the Glass Transition Temperatures by Differential Scanning Calorimetry; ASTM International: West Conshohocken, PA, USA, 2008; Volume 8, pp. 1–4. [Google Scholar]
- Crank, J. The Mathematics of Diffusion; Oxford Univerity: Oxford, UK, 1975; p. 414. [Google Scholar]
- Lim, L.-T.; Tung, M.A. Vapor pressure of allyl isothiocyanate and its transport in PVDC/PVC copolymer packaging film. J. Food Sci. 1997, 62, 1061–1062. [Google Scholar] [CrossRef]
- Cran, M.J.; Rupika, L.A.S.; Sonneveld, K.; Miltz, J.; Bigger, S.W. Release of naturally derived antimicrobial agents from LDPE films. J. Food Sci. 2010, 75, E126–E133. [Google Scholar] [CrossRef] [PubMed]
- Suppakul, P.; Sonneveld, K.; Bigger, S.W.; Miltz, J. Diffusion of linalool and methylchavicol from polyethylene-based antimicrobial packaging films. LWT Food Sci. Technol. 2011, 44, 1888–1893. [Google Scholar] [CrossRef]
- Miltz, J. Migration of Low Molecular Weight Species from Packaging Materials: Theoretical and Practical Considerations; Technomic Publishing Co.: Lancaster, UK, 1987. [Google Scholar]
- ASTM-D882-12. Standard Test Method for Tensile Properties of Thin Plastic Sheeting; ASTM International: West Conshohocken, PA, USA, 2012. [Google Scholar]
- Cardiet, G.; Fuzeau, B.; Barreau, C.; Fleurat-Lessard, F. Contact and fumigant toxicity of some essential oil constituents against a grain insect pest sitophilus oryzae and two Fungi, aspergillus westerdijkiae and fusarium graminearum. J. Pest Sci. 2012, 85, 351–358. [Google Scholar] [CrossRef]
- Knani, D.; Barkay-Olami, H.; Alperstein, D.; Zilberman, M. Simulation of novel soy protein-based systems for tissue regeneration applications. Polym. Adv. Technol. 2017, 28, 496–505. [Google Scholar] [CrossRef]
- Lecouvet, B.; Sclavons, M.; Bourbigot, S.; Devaux, J.; Bailly, C. Water-assisted extrusion as a novel processing route to prepare polypropylene/halloysite nanotube nanocomposites: Structure and properties. Polymer 2011, 52, 4284–4295. [Google Scholar] [CrossRef]
- Du, M.; Guo, B.; Jia, D. Thermal stability and flame retardant effects of halloysite nanotubes on poly(propylene). Eur. Polym. J. 2006, 42, 1362–1369. [Google Scholar] [CrossRef]
- Ramos, M.; Beltrán, A.; Peltzer, M.; Valente, A.J.M.; Garrigós, M.d.C. Release and antioxidant activity of carvacrol and thymol from polypropylene active packaging films. LWT Food Sci. Technol. 2014, 58, 470–477. [Google Scholar] [CrossRef]
- Pal, P.; Kundu, M.K.; Malas, A.; Das, C.K. Compatibilizing effect of halloysite nanotubes in polar–nonpolar hybrid system. J. Appl. Polym. Sci. 2014, 131. [Google Scholar] [CrossRef]
- Khunova, V.; Kristóf, J.; Kelnar, I.; Dybal, J. The effect of halloysite modification combined with in situ matrix modifications on the structure and properties of polypropylene/halloysite nanocomposites. Express Polym. Lett. 2013, 7, 471–479. [Google Scholar] [CrossRef]
- Socrates, G. Infrared and Raman Characteristics Group Frequencies; Wiley & Sons Ltd.: New York, NY, USA, 2001. [Google Scholar]
- López De Dicastillo, C.; Castro-López, M.D.M.; Lasagabaster, A.; López-Vilariño, J.M.; González-Rodríguez, M.V. Interaction and release of catechin from anhydride maleic-grafted polypropylene films. ACS Appl. Mater. Interfaces 2013, 5, 3281–3289. [Google Scholar] [CrossRef] [PubMed]
- Tabatabaei, S.H.; Carreau, P.J.; Ajji, A. Effect of processing on the crystalline orientation, morphology, and mechanical properties of polypropylene cast films and microporous membrane formation. Polymer 2009, 50, 4228–4240. [Google Scholar] [CrossRef]
- Sperling, L.H. Mechanical Behavior of Polymers. In Introduction to Physical Polymer Science; John Wiley & Sons, Inc.: New York, NY, USA, 2005; pp. 557–612. [Google Scholar]
- Liu, M.; Guo, B.; Du, M.; Chen, F.; Jia, D. Halloysite nanotubes as a novel β-nucleating agent for isotactic polypropylene. Polymer 2009, 50, 3022–3030. [Google Scholar] [CrossRef]
- Liu, M.; Jia, Z.; Liu, F.; Jia, D.; Guo, B. Tailoring the wettability of polypropylene surfaces with halloysite nanotubes. J. Colloid Interface Sci. 2010, 350, 186–193. [Google Scholar] [CrossRef] [PubMed]
- Lieberman, R.; Stewart, C. Propylene Polymers. In Encyclopedia of Polymer Science and Technology; John Wiley & Sons, Inc.: New York, NY, USA, 2002. [Google Scholar]
- Liu, Q.; Sun, X.; Li, H.; Yan, S. Orientation-induced crystallization of isotactic polypropylene. Polymer 2013, 54, 4404–4421. [Google Scholar] [CrossRef]
- Auriemma, F.; De Rosa, C.; Corradini, P. Solid mesophases in semicrystalline polymers: Structural analysis by diffraction techniques. Adv. Polym. Sci. 2005, 181, 1–74. [Google Scholar]
- Larkin, P. Chapter 2—Basic Principles. In Infrared and Raman Spectroscopy; Elsevier: Oxford, UK, 2011; pp. 7–25. [Google Scholar]
- Lamberti, G.; Brucato, V. Real-time orientation and crystallinity measurements during the isotactic polypropylene film-casting process. J. Polym. Sci. Part B Polym. Phys. 2003, 41, 998–1008. [Google Scholar] [CrossRef]
- Solano, A.C.V.; Rojas Gante, C. Two different processes to obtain antimicrobial packaging containing natural oils. Food Bioprocess Technol. 2012, 5, 2522–2528. [Google Scholar] [CrossRef]
- Notta-Cuvier, D.; Murariu, M.; Odent, J.; Delille, R.; Bouzouita, A.; Raquez, J.-M.; Lauro, F.; Dubois, P. Tailoring polylactide properties for automotive applications: Effects of co-addition of halloysite nanotubes and selected plasticizer. Macromol. Mater. Eng. 2015, 300, 684–698. [Google Scholar] [CrossRef]
- Ouali, L.; Léon, G.; Normand, V.; Johnsen, H.; Dyrli, A.; Schmid, R.; Benczedi, D. Mechanism of romascone® release from hydrolyzed vinyl acetate nanoparticles: Thermogravimetric method. Polym. Adv. Technol. 2006, 17, 45–52. [Google Scholar] [CrossRef]
- Ward, C.J.; Song, S.; Davis, E.W. Controlled release of tetracycline-hcl from halloysite-polymer composite films. J. Nanosci. Nanotechnol. 2010, 10, 6641–6649. [Google Scholar] [CrossRef] [PubMed]
- Lecouvet, B.; Sclavons, M.; Bourbigot, S.; Bailly, C. Thermal and flammability properties of polyethersulfone/halloysite nanocomposites prepared by melt compounding. Polym. Degrad. Stabil. 2013, 98, 1993–2004. [Google Scholar] [CrossRef]
- Tham, W.L.; Chow, W.S.; Poh, B.T.; Ishak, Z.A.M. Poly(lactic acid)/halloysite nanotube nanocomposites with high impact strength and water barrier properties. J. Compos. Mater. 2016, 50, 3925–3934. [Google Scholar] [CrossRef]
- Pitt, J.I.; Hocking, A.D. Spoilage of stored, processed and preserved foods. In Fungi and Food Spoilage; Springer: Boston, MA, USA, 2009; pp. 401–421. [Google Scholar]
- Lambert, R.J.W.; Skandamis, P.N.; Coote, P.J.; Nychas, G.J.E. A study of the minimum inhibitory concentration and mode of action of oregano essential oil, thymol and carvacrol. J. Appl. Microbiol. 2001, 91, 453–462. [Google Scholar] [CrossRef] [PubMed]
- Farag, R.S.; Daw, Z.Y.; Aboraya, S.H. Influence of some spice essential oils on aspergillus-parasiticus growth and production of aflatoxins in a synthetic medium. J. Food Sci. 1989, 54, 74–76. [Google Scholar] [CrossRef]

| Film Name | Composition (% w/w) | ||
|---|---|---|---|
| PP | HNTs | Carvacrol | |
| PP | 100 | 0 | 0 |
| PP/HNTs | 98 | 2 | 0 |
| PP/carvacrol | 96 | 0 | 4 |
| PP/(HNTs-carvacrol) | 94 | 2 | 4 |
| Polymer Films | Pre-Processing Content of Carvacrol, % w/w | Post-Processing Content of Carvacrol by TGA, % w/w |
|---|---|---|
| PP | None | 0.0 ± 0.0 |
| PP/HNTs | None | 0.0 ± 0.0 |
| PP/carvacrol | 4 | 3.1 ± 0.1 |
| PP/(HNTs-carvacrol) | 4 | 3.1 ± 0.1 |
| Materials and Their Combinations | δ, MPa0.5 | ΔHmix, MJ·m−3 |
|---|---|---|
| PP | 20.05 | |
| Carvacrol | 23.36 | |
| HNTs | 23.77 | |
| PP-HNTs | 17.36 | −107 |
| PP-HNTs-carvacrol | 17.05 | −103 |
| Polymer Film | DSC | FTIR | WAXS | |||||
|---|---|---|---|---|---|---|---|---|
| Tm1 | Tm2 | Tc | Tg(o) | cm1 (%) | cm2 (%) | A841/A973 | c (%) | |
| PP | 167 (1) | 166 (0) | 123 (1) | 0 (0) | 37 (0) | 44 (1) | 0.54 (0.00) | 46 (1) |
| PP/HNTs | 168 (1) | 167 (0) | 123 (0) | 0 (0) | 38 (1) | 44 (1) | 0.57 (0.00) | 48 (1) |
| PP/carvacrol | 168 (0) | 166 (0) | 121 (0) | −7 (0) | 39 (0) | 43 (1) | 0.48 (0.00) | 41 (1) |
| PP/(HNTs-carvacrol) | 167 (1) | 166 (0) | 122 (0) | −6 (0) | 40 (1) | 43 (1) | 0.54 (0.00) | 46 (1) |
| Samples | Along Machine Direction | Along Transverse Direction | ||||
|---|---|---|---|---|---|---|
| Yield Stress, MPa | Tensile Stress at Break, MPa | Elongation at Break, % | Yield Stress, MPa | Tensile Stress at Break, MPa | Elongation at Break, % | |
| PP | 33 (1) | 49 (2) | 605 (34) | 32 (1) | 31 (1) | 8 (1) |
| PP/HNTs | 32 (1) | 54 (6) | 607 (50) | 29 (1) | 28 (2) | 5 (1) |
| PP/carvacrol | 17 (1) | 48 (3) | 663 (23) | 17 (1) | 25 (4) | 499 (59) |
| PP/(HNTs-carvacrol) | 24 (1) | not observed | >700 | 23 (1) | 33 (1) | 643 (28) |
| Polymer Film | Carvacrol Diffusivity, ×1013·m2·s−1 |
|---|---|
| PP/carvacrol | 9.42 (0.82) |
| PP/(HNTs-carvacrol) | 6.99 (0.61) |
© 2018 by the authors. Licensee MDPI, Basel, Switzerland. This article is an open access article distributed under the terms and conditions of the Creative Commons Attribution (CC BY) license (http://creativecommons.org/licenses/by/4.0/).
Share and Cite
Krepker, M.; Prinz-Setter, O.; Shemesh, R.; Vaxman, A.; Alperstein, D.; Segal, E. Antimicrobial Carvacrol-Containing Polypropylene Films: Composition, Structure and Function. Polymers 2018, 10, 79. https://doi.org/10.3390/polym10010079
Krepker M, Prinz-Setter O, Shemesh R, Vaxman A, Alperstein D, Segal E. Antimicrobial Carvacrol-Containing Polypropylene Films: Composition, Structure and Function. Polymers. 2018; 10(1):79. https://doi.org/10.3390/polym10010079
Chicago/Turabian StyleKrepker, Max, Ofer Prinz-Setter, Rotem Shemesh, Anita Vaxman, David Alperstein, and Ester Segal. 2018. "Antimicrobial Carvacrol-Containing Polypropylene Films: Composition, Structure and Function" Polymers 10, no. 1: 79. https://doi.org/10.3390/polym10010079
APA StyleKrepker, M., Prinz-Setter, O., Shemesh, R., Vaxman, A., Alperstein, D., & Segal, E. (2018). Antimicrobial Carvacrol-Containing Polypropylene Films: Composition, Structure and Function. Polymers, 10(1), 79. https://doi.org/10.3390/polym10010079

